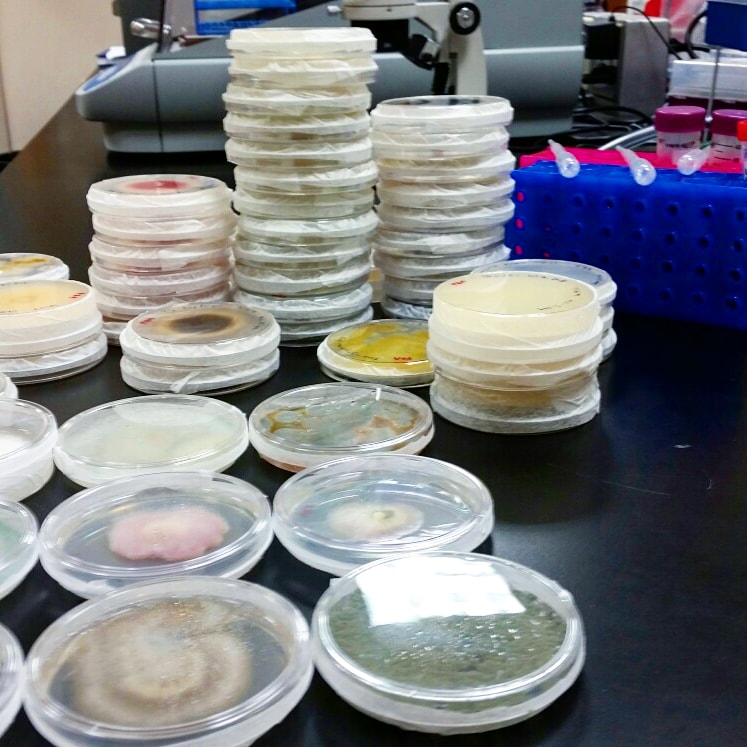

The objective of this research was to isolate endophytic fungi found in Huperzia lucidula and identify their Acetylcholinesterase (AChE) enzyme inhibiting abilities. Due to the suggestion that AChE inhibition has the potential to act as an early treatment to Alzheimer’s Disease.
This project received funding from the Appalachian State University Undergraduate Research College and the Tom and Bruce Shinn Scholarship
Specific Techniques/Skills Used:
- Extraction/Distillation
- Tissue Culture
- Isolation of Endophytes
- Identification by Molecular DNA extraction
- Enzyme Inhibition Assay
- Microscopy
- Plant Care/Maintenance
- Grant/Prospectus Writing